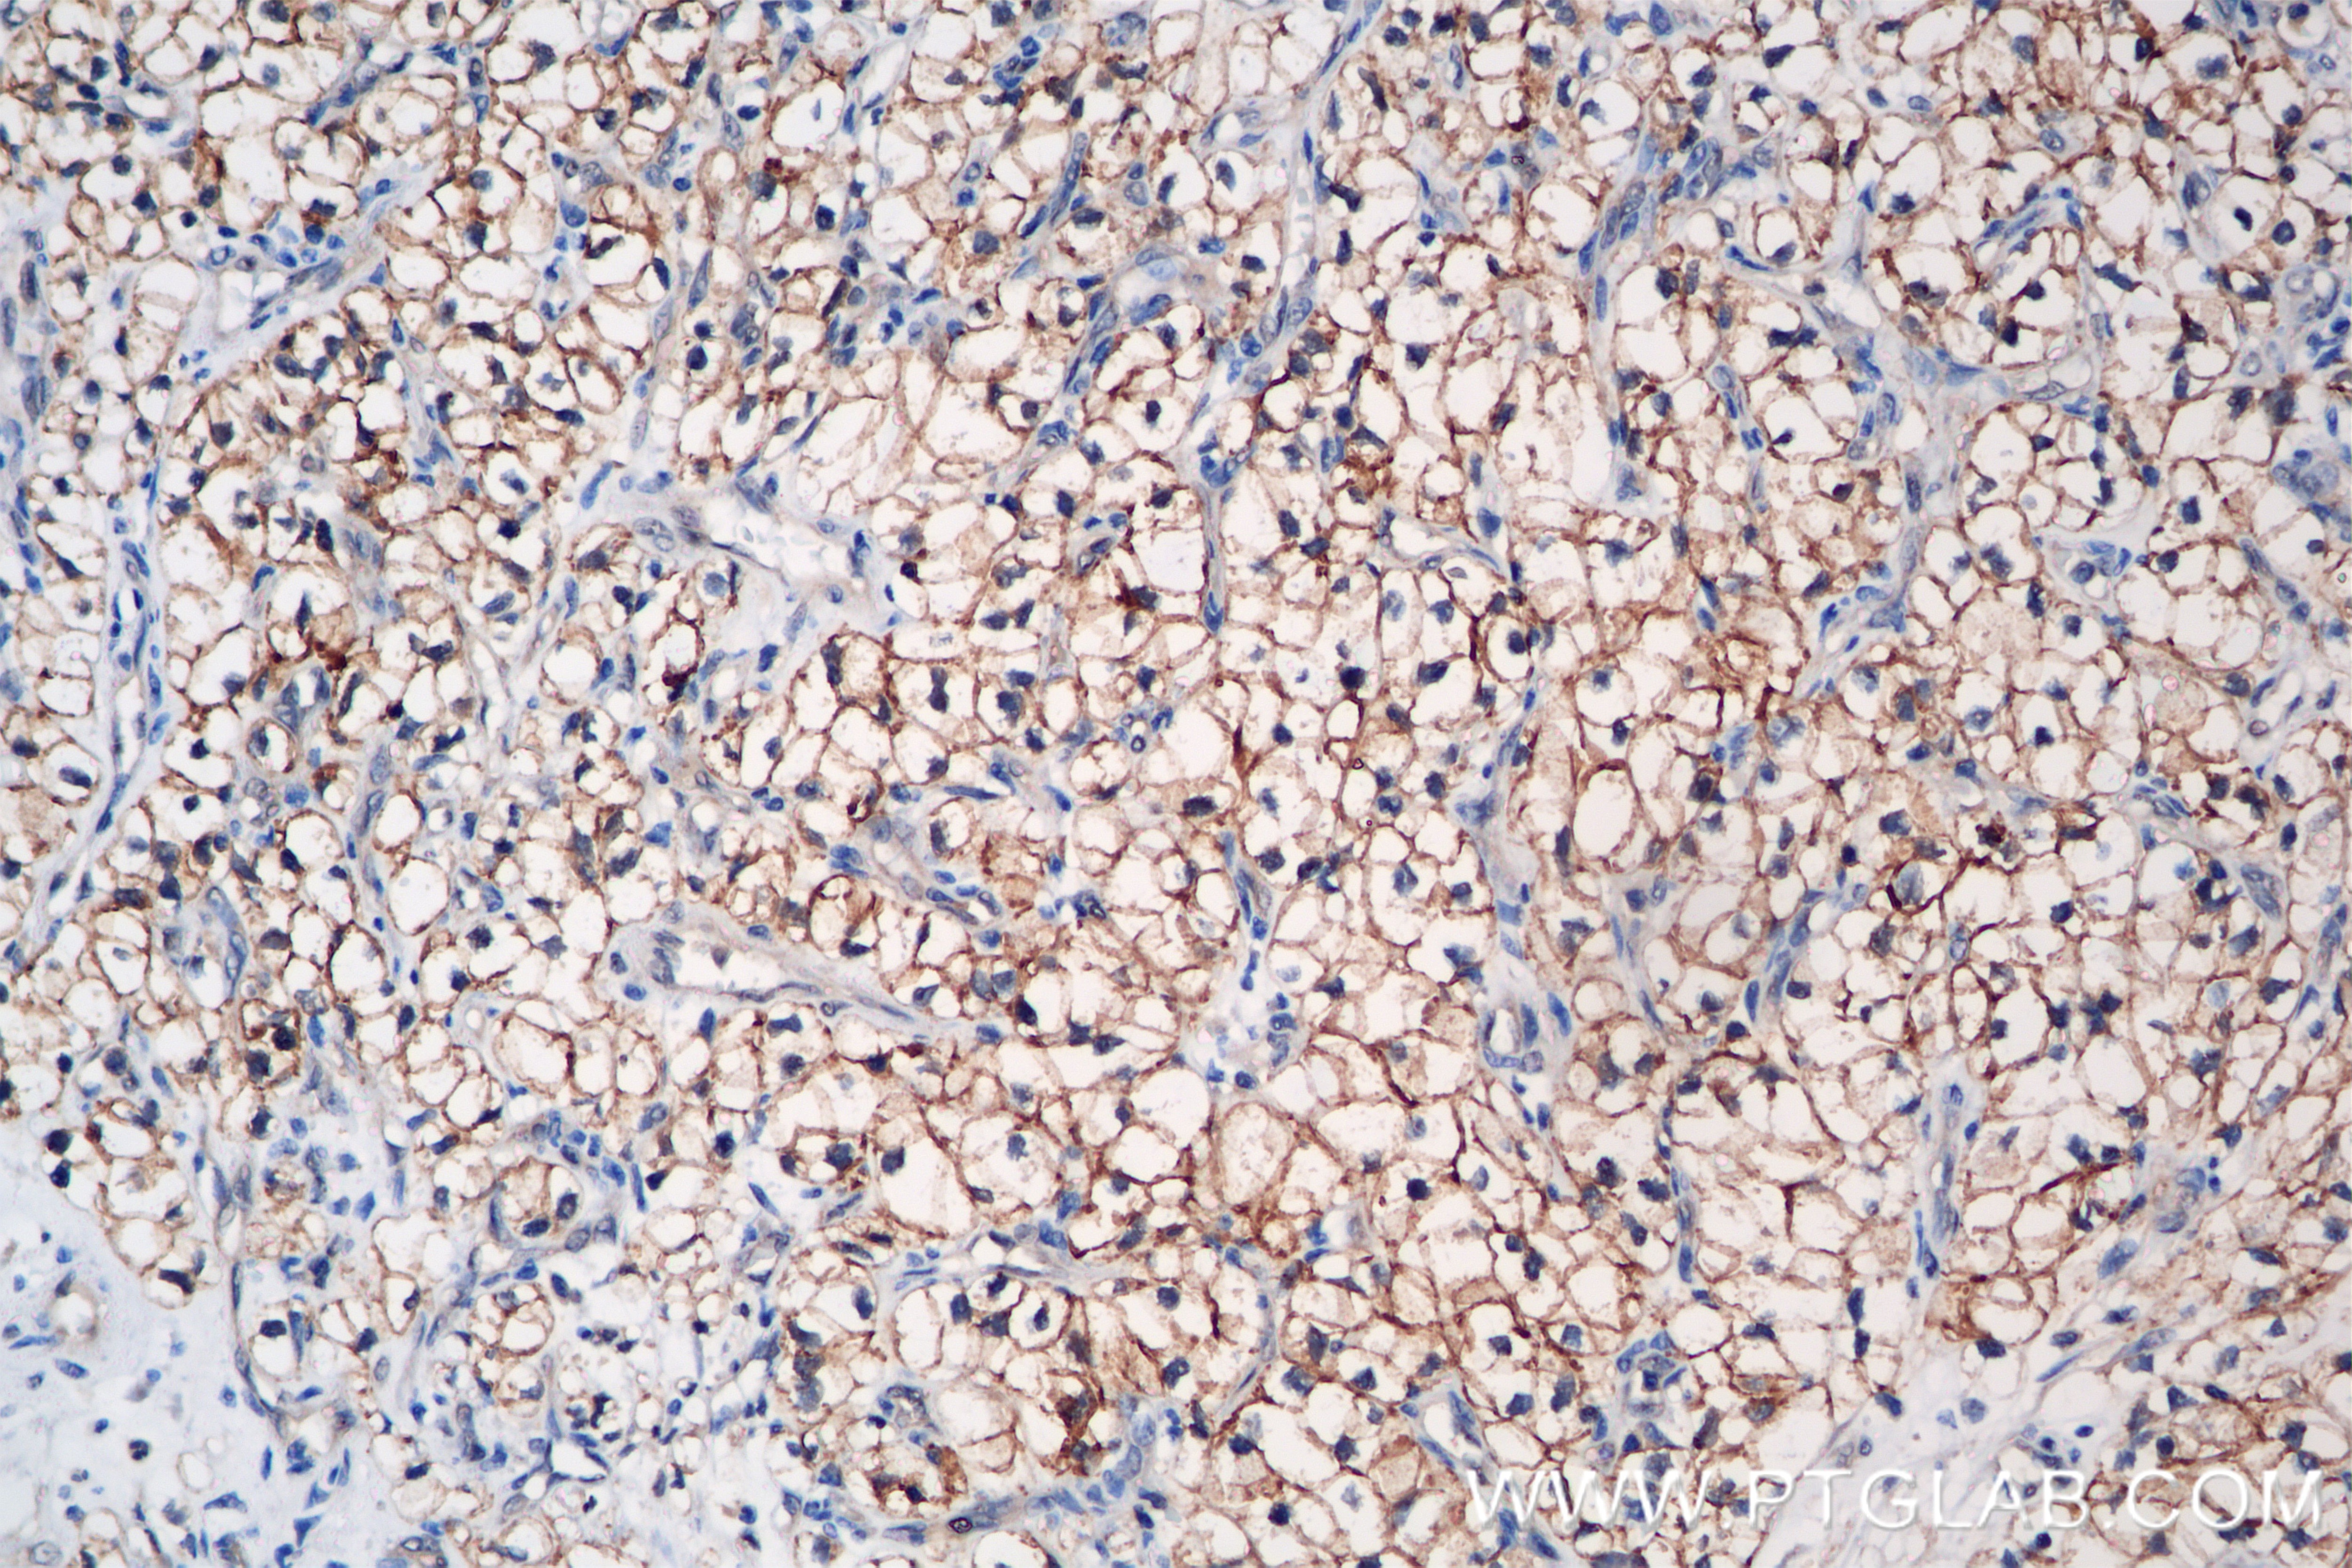

Anticorps Recombinant de lapin anti-GGT1
GGT1 Recombinant Antibody for WB, IHC, Indirect ELISA
Hôte / Isotype
Lapin / IgG
Réactivité testée
Humain
Applications
WB, IHC, Indirect ELISA
Conjugaison
Non conjugué
CloneNo.
230428B5
N° de cat : 83304-1-PBS
Synonymes
Galerie de données de validation
Applications testées
| Résultats positifs en IHC | Human Kidney(renal cell) Cancer, il est suggéré de démasquer l'antigène avec un tampon de TE buffer pH 9.0; (*) À défaut, 'le démasquage de l'antigène peut être 'effectué avec un tampon citrate pH 6,0. |
Dilution recommandée
| Application | Dilution |
|---|---|
| Immunohistochimie (IHC) | IHC : 1:400-1:1600 |
| It is recommended that this reagent should be titrated in each testing system to obtain optimal results. | |
| Sample-dependent, check data in validation data gallery | |
Informations sur le produit
83304-1-PBS cible GGT1 dans les applications de WB, IHC, Indirect ELISA et montre une réactivité avec des échantillons Humain
| Réactivité | Humain |
| Hôte / Isotype | Lapin / IgG |
| Clonalité | Recombinant |
| Type | Anticorps |
| Immunogène | GGT1 Protéine recombinante Ag34209 |
| Nom complet | gamma-glutamyltransferase 1 |
| Masse moléculaire calculée | 61 kDa |
| Poids moléculaire observé | 24 kDa |
| Numéro d’acquisition GenBank | NM_013430 |
| Symbole du gène | GGT1 |
| Identification du gène (NCBI) | 2678 |
| Conjugaison | Non conjugué |
| Forme | Liquide |
| Méthode de purification | Protein A purfication |
| Tampon de stockage | PBS only |
| Conditions de stockage | Store at -80°C. 20ul contiennent 0,1% de BSA. |
Informations générales
GGT1 is a transpeptidase whose activity increases the availability of amino acids, primarily cysteine, for intracellular GSH synthesis. GGT1 also plays a critical role in maintaining GSH homeostasis and defense against oxidative stress. In liver and obstructive biliary diseases, circulating GGT1 activity has widely been used for diagnosis purposes, as well as an indicator of alcohol consumption. (PMID: 31151999)
Protocole
| Product Specific Protocols | |
|---|---|
| IHC protocol for GGT1 antibody 83304-1-PBS | Download protocol |
| Standard Protocols | |
|---|---|
| Click here to view our Standard Protocols |